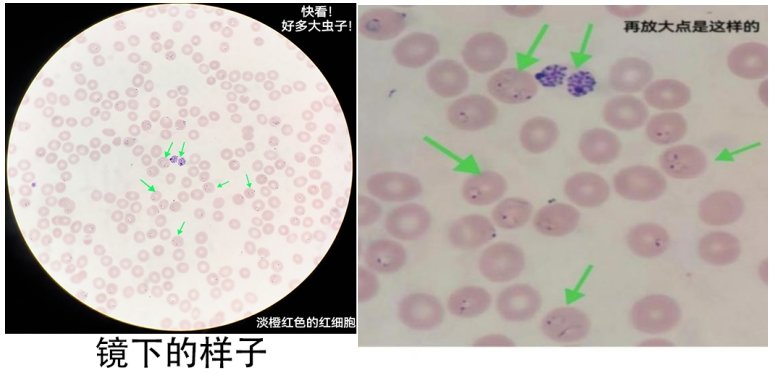
图片

- 24小时服务电话
- 0537-6056666
-
微信服务号
-
微信订阅号
-
微信视频号
-
抖音号

科普园地
每年4月25日是世界防治疟疾日,我国将4月26日定为“全国疟疾日”,以进一步强化疟疾防控意识。2025年正值第18个世界防治疟疾日暨“全国疟疾日”,世界卫生组织呼吁全球行动,提出主题:“Malaria Ends with Us: Reinvest, Reimagine, Reignite”(“终结疟疾始于你我:再投入、再创新、再燃斗志”),旨在动员全社会共同参与疟疾防治。
我国“全国疟疾日”的宣传主题为“严防输入再传播,巩固消除疟疾成果”,强调在全球化背景下,需持续加强疟疾监测与防控,防止境外输入病例引发本地传播,巩固来之不易的消除疟疾成果。

一、认识疟疾:危险的“打摆子”
疟疾是由疟原虫感染引起的蚊媒传染病,俗称“打摆子”。临床可表现为周期性寒战、高热、大汗、脾肿大及贫血。其中,恶性疟致死率较高,若不及时规范治疗,可能迅速进展为重症疟疾,引发脑型疟(昏迷)、急性肾衰竭甚至死亡。
目前感染人类的疟原虫主要有4种:
间日疟原虫、恶性疟原虫、三日疟原虫和卵形疟原虫,分别引起间日疟、恶性疟、三日疟和卵形疟。
近年发现,东南亚的诺氏疟原虫(猕猴宿主)也可感染人类。
二、全球流行现状:输入性风险不可忽视
全球估计有2.63亿疟疾病例,83个国家流行,其中非洲占94%,其次为东南亚、东地中海、西太平洋和南美洲地区。我国虽已消除本地疟疾,但每年仍有大量的输入性病例,传播媒介(按蚊)尚未消失,再传播风险持续存在。
三、疟原虫的发育繁殖和传播途径
1、发育繁殖:在人体内可分为红细胞外(即肝细胞内)裂殖阶段和红细胞内裂殖阶段。
①受感染的蚊子吸血时,子孢子进入血液,在肝细胞内发育成裂殖子,从肝细胞逸出,部分裂殖子侵入红细胞内发育。
②红细胞内裂殖体破裂,同时使红细胞崩解,裂殖子进入新的红细胞,患者即产生一次临床发作。部分裂殖子在红细胞内不再进行裂体增殖,而发育为配子体。
蚊子吸血,吸入配子体,在蚊体内发育形成子孢子。
这就是疟原虫的前世今生。

2、传播途径:蚊子、血液与母婴
①主要传播方式:被携带疟原虫的按蚊叮咬(库蚊、伊蚊不传播疟疾)。
小知识:按蚊(疟蚊)与其他常见蚊子的区别?
咱们经常见的蚊子有三种:库蚊(家蚊),伊蚊(“花蚊子”),按蚊(疟蚊)。请看下图:

②其他途径:输入含疟原虫的血液;孕妇感染疟疾传播给胎儿-母婴垂直传播(多见于非洲地区)。
日常接触(如与疟疾患者握手、同坐、共同进食等)不会造成传播。
四、诊断:早发现是关键
1.流行病学史
近期有疟疾流行区旅居史、输血史或既往疟疾病史。
2.临床表现

周期性寒战-高热-大汗退热三联征,或发热不规则。症状通常在被受感染的蚊子叮咬后10-15天内开始。
3.实验室检查
①根据疟原虫的生长特点,可以通过显微镜检查在外周血里发现疟原虫,这也是疟疾诊断的金标准。
我们需要采集血液,制备血涂片,染色,镜检(厚血膜在油镜下,最少检查100个视野或整个厚血膜未查见疟原虫方可判为阴性,一旦在厚血膜里发现虫子,还要去薄血膜里进一步鉴别虫种),经过这一系列的过程才能发出一份准确的报告。
②抗原检测阳性
疟原虫抗原检测(胶体金法),快速筛查,简便快捷。
③核酸检测(PCR)阳性
高灵敏度,目前仅在疟疾诊断参比实验室开展。
五、治疗:精准用药,规范疗程
抗疟药物分为两类:
1.杀灭红内期疟原虫药物(“控制临床发作药物”):如氯喹、青蒿素类复方等。
2.杀灭肝内期疟原虫药物(“抗复发药物”):如伯氨喹。
治疗方案需由医生根据虫种、患者状况制定,避免滥用药物导致耐药。
六、预防:防蚊为主,警惕输入

天气转暖,空气湿润,蚊虫活跃起来,出去旅行的小伙伴们要注意防蚊、灭蚊。
1.个人防护:长袖衣物,驱蚊手环、驱蚊花露水、蚊香等驱蚊剂,蚊帐(疟疾流行区推荐药浸蚊帐)。
2.旅行建议:如不可避免前往疟疾流行区需提前咨询,归国后一旦出现发热等症状,应尽快到专业机构就诊,并主动告知医生疟疾流行区旅居史,以实现疟疾早诊断、早治疗,以免延误诊治,危及生命!
3.环境治理:清除积水,减少蚊虫孳生。